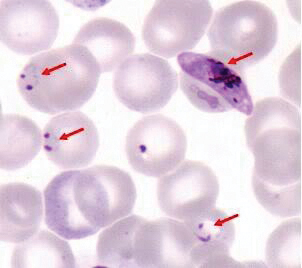

Treatment of aspergillus
ABPA –> Steroids + Itraconazole Invasive aspergillosis –> Voriconazole
Treatment of mucormycosis
Amphotericin
Treatment of cryptococcosis
Amphotericin B + Flucytosis (followed by fluconazole consolidation therapy)
Distribution of Blastomycosis
Midwestern, southeastern, and south central US (Mississippi, Missouri, and Ohio river valleys)
Distribution of Coccidiomycosis
Southern Arizona South central California Southwestern New Mexico West Texas
Distribution of Histoplasmosis
Midwestern states in the Ohio and Mississippi River Valleys
2007 AHA Indications for Endocarditis Prophylaxis
(1) Prosthetic cardiac valve (2) History of infective endocarditis (3) Certain types of congenital heart disease - unrepaired cyanotic congenital heart disease include palliative shunts and conduits, a completely repaired congenital heart defect with prosthetic material or device during the first 6 months post-procedure, repaired congenital heart disease with residual defects (4) Cardiac transplant recipients in whom valvulopathy develops
The only statin with proven benefit in HIV patients
Atorvastatin
Preferred antiretroviral regimen in pregnancy
zidovudine, lamivudine, and lopinavir/ritonavir
Diseases transmitted by the deer tick
(1) Lyme disease (2) Babesiosis (3) Anaplasmosis
Treatment of babesiosis
Quinine + clindamycin OR atovaquone + azithromycin
Fungal infection associated with “halo sign” on chest CT
Aspergillosis
Prophylaxis for exposure to meningococcus meningitis
Rifampin, ceftriaxine, ciprofloxacin
Species of Plasmodium that causes multiply-infected erythrocytes
P. falciparum
Alternate treatment for P. falciparum
Artemether-lumefantrine (Coartem)
Drug of choice for malaria prophylaxis in pregnancy
Mefloquine
Tick-borne disease that causes pneumonia or ulcer with regional LAD
Tularemia (Francisella tularensis)
Species of malaria that involves hypnozoites in the liver
P. vivax and P. ovale Requires primaquine for eradication
Positive PPD if >5mm
- HIV positive - Recent contacts of persons with active TB - Fibrotic changes on CXR c/w old TB - Organ transplants and other immunosuppressive conditions (e.g. chronic prednisone)
Positive PPD if >10mm
- Recent (<5 yr) arrival from high-prevalence countries - Injection drug users - Residents or employees of high-risk congregate settings - Mycobacteriology laboratory personnel
Plasmodium falciparum
Characterized by ring forms, some of which may be multiple, positioned along the periphery of the erythrocyte against the inner surface of its membrane. Classic “banana-shaped” gametocytes, if detected, can help to distinguish falciparum malaria species from the other potential Plasmodium species.
RIPE drug associated with hyperuricemia
Pyrazinamide
Outpatient treatment of PID
Parenteral ceftriaxone, cefotaxime, or ceftizoxime
+
Doxycycline
+/-
Metroniadzole
Inpatient antibiotics for PID
Parenteral cefoxitin or cefotetan (2nd gen)
+
Doxycycline


